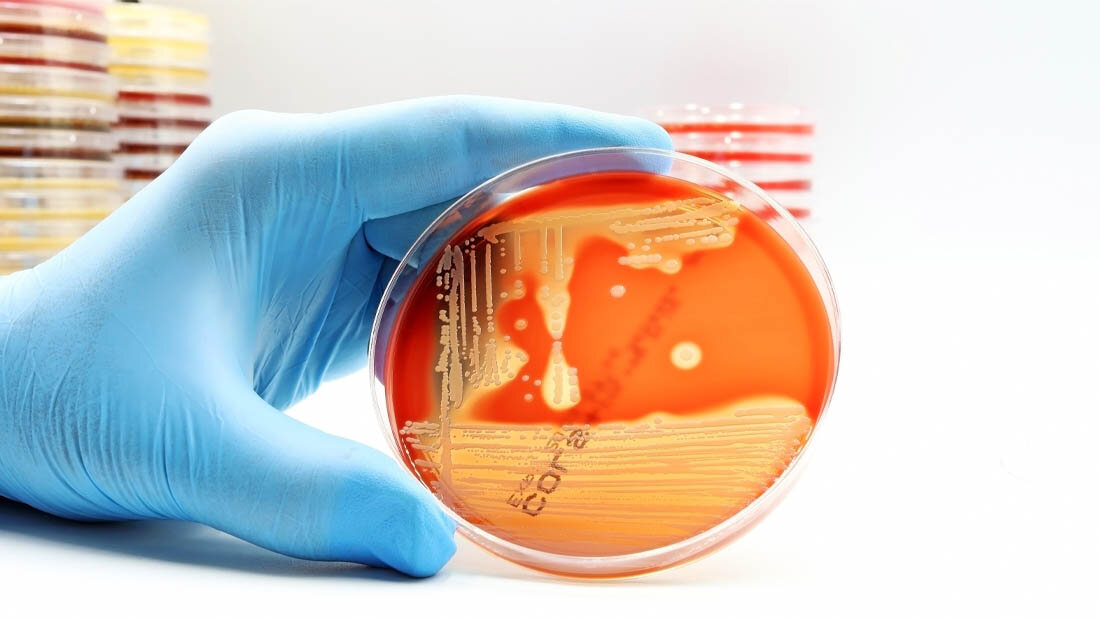
MRSA

Die unkontrollierte Einfuhr von Fleisch kann eine große Gefahr für die Gesundheit bedeuten und die Verbreitung von antibiotikaresistenten Bakterien begünstigen. Forscher der TiHo und des InfectoGnostics Partners Alere Technologies GmbH, Jena, konnten zeigen, dass Fleischwaren, die von Flugpassagieren illegal importiert wurden, mit multiresistenten Bakterien kontaminiert waren. Die Wissenschaftler identifizierten Bakterien-Stämme, die bereits gegen mehrere Antibiotika resistent waren und verschiedene Virulenzfaktoren – also krankmachende Merkmale – aufwiesen. Das Forscherteam stellte zudem fest, dass die Keime nicht vom Tier selbst stammten, sondern menschlichen Ursprungs waren und somit auf mangelnde Hygiene-Standards bei der Schlachtung und Verarbeitung hindeuten.
Bakterien tauschen genetische Informationen aus
Werden kontaminierte Nahrungsmittel aus Nicht-EU-Staaten importiert, können sich Menschen und Tiere auch in der EU mit diesen Bakterienstämmen infizieren, die mit vielfältigen Resistenz- und Virulenzfaktoren ausgestattet sind. Diese Faktoren können sie dann außerdem auf hiesige Erreger übertragen. Eine besondere Rolle spiele dabei der sogenannte horizontale Gentransfer, erläutert Dr. Ralf Ehricht, Leiter für Machbarkeitsstudien in Forschung und Entwicklung bei Alere Technologies: „Viele Bakterien sind in der Lage, genetische Informationen nicht nur durch Vermehrung, sondern auch innerhalb einer Generation – sozusagen mit ihren Nachbarn – auszutauschen. Sobald ein solcher übertragbarer Resistenzfaktor etabliert wurde, kann er auf diese Weise sehr rasch auf andere Bakterienstämme übertragen werden.“
Für ihre Untersuchung isolierten die Wissenschaftler die Bakterien und bestimmten anschließend durch Gen-Analysen deren Abstammung, Virulenzfaktoren sowie vorhandene Antibiotika-Resistenzdeterminanten. Für die Erfassung und Analyse der genetischen Eigenschaften der Bakterien nutzten die Forscher ein spezielles Alere-Microarray. Mit diesem molekularbiologischen Testverfahren lassen sich mehrere hundert molekulare Parameter gleichzeitig auf einer winzigen Testfläche bestimmen.
2,8 Tonnen illegal importiertes Fleisch in einem Jahr
Grundlage für die Studie waren Proben von den Flughäfen Frankfurt und Berlin-Schönefeld. Allein im Jahr 2014 wurden an diesen beiden Flughäfen insgesamt 2,8 Tonnen Fleisch illegal von Passagieren mitgeführt. Solche illegalen Importe – oftmals unter mangelnden Hygiene-Standards außerhalb der EU produziert und ungekühlt im Gepäck transportiert – erhöhen nach Ansicht der Forscher das Risiko einer aktuellen Verbreitung multiresistenter Bakterien in Europa. (InfectoGnostics, red)
Literatur:
Anja Müller, Diana Seinige, Wiebke Jansen et al.: Variety of Antimicrobial Resistances and Virulence Factors in Staphylococcus aureus Isolates from Meat Products Legally and Illegally Introduced to Germany. PLOS ONE, published: December 9, 2016, DOI: 10.1371/journal.pone.0167864.
Artikel teilen